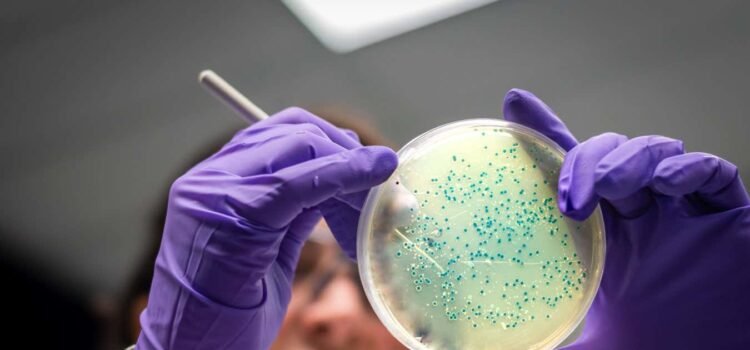

Book Review: How One Weird Rodent Ecologist Tried to Change the Fate of Humanity
September 17, 20243 min readBook Review: How One Weird Rodent Ecologist Tried to Change the Fate of HumanityA biography of the scientist whose work led to fears of a ‘population bomb’By Ben Goldfarb NONFICTIONDr. Calhoun's Mousery: The Strange Tale of...